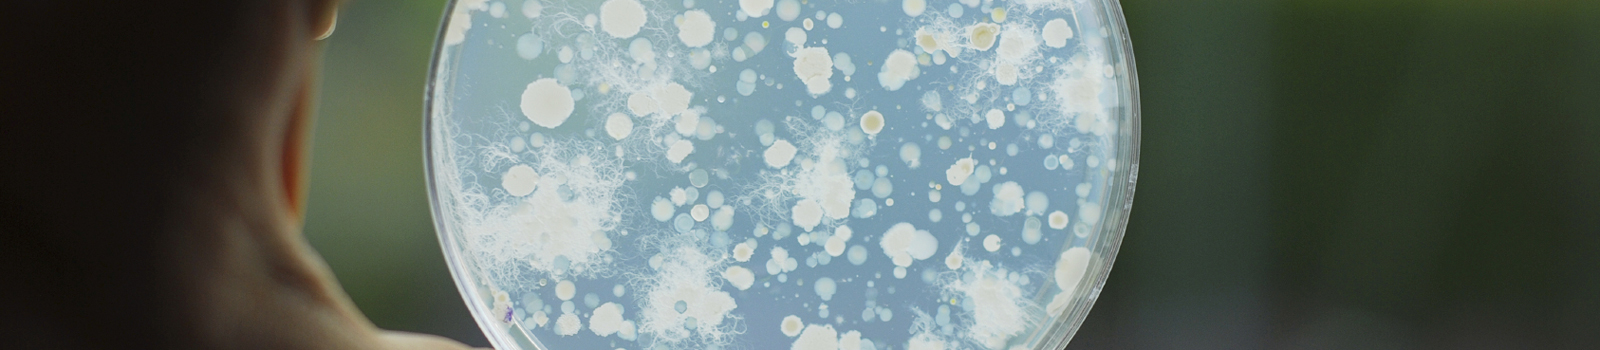

Mikrobieller Schadstoffabbau
Mikrobieller Schadstoffabbau
Mikrobielle Schadstoffeliminierung
Mikroorganismen sind in der Lage, Schadstoffe im Boden, Grund- oder Abwasser abzubauen. Indem wir diese Prozesse in unseren Laboren simulieren, lässt sich feststellen, wie und wie schnell Abbauprozesse im entsprechender Matrix ablaufen.
Dienstleistungen der Eurofins Umwelt-Gesellschaften
Unser Projektlabor ist auf die Durchführung von Machbarkeitsstudien zur mikrobiellen Schadstoffeliminierung im Boden, im Grundwasser sowie im Abwasser spezialisiert. Dafür stehen moderne Untersuchungseinrichtungen bereit, um Eliminierungsprozesse im Batch- und im Durchlaufverfahren simulieren zu können. Wir sind in der Lage, auch vielschichtige Aufgaben des Schadstoffabbaus im Labor zielführend und effizient zu lösen. Das enge Ineinandergreifen von Versuchsbetreuung, apparativer Analytik, mikrobiologischer und ökotoxikologischer Begleituntersuchung ist Grundlage der Qualität unserer Arbeit - komplexe umweltbiotechnologische Laborleistungen, bereitgestellt aus einer Hand. Unsere Untersuchungen umfassen:
Grundwasser und Boden
- Durchführung von Labor-Batch- und Säulenversuchen (aerob, anaerob)
- Mikrokosmentests
- Mikrobiologische Analysen (Zellzahlen, Stoffwechselgruppen, Schadstoffverwerter)
- Bilanzierung von Elektronenakzeptoren sowie weiterer stoffwechselrelevanter Parameter
- Bestimmung der mikrobiellen Aktivität
- Schadstoffanalytik und Analytik von Metaboliten des mikrobiellen Abbaus
- Ökotoxikologische Untersuchungen mit aquatischen, terrestrischen und zellbasierten Testsystemen
Abwasser
- Abbau gefährlicher Abwasserinhaltsstoffe in Laborkläranlagen (Belebungs- und Festbettverfahren)
- Schadstoffanalytik im Abwasser, Belebtschlamm und Biofilm
- Bilanzierung der Eliminierung und des Verbleibs von Wasserschadstoffen
- Ökotoxikologische Untersuchungen mit aquatischen Testsystemen